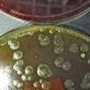
不是厕所是厨房

在很多人看来,卫生间是一个家庭细菌最多、最脏的地方,而厨房因为是制作食品的地方,应该是最干净的地方。
事实真的如此吗?华商报记者联合西安交大医学部免疫学与病原生物学系微生物学实验室,通过实验为你揭晓答案。
一个误区
走访10人 8人认为厕所细菌最多
你觉得家里最脏、细菌最多的部位是哪里?带着这个问题,华商报记者走访了10名西安市民,其中8位不假思索地认为厕所最脏、细菌最多。刘先生说:“肯定是厕所,家里最脏的东西都在厕所,这还用怀疑吗?”胡女士认为:“厕所除了用来大小便,一般还要洗脸刷牙洗衣服,最容易滋生细菌,我觉得厕所最脏。”也有人认为最脏的地方是客厅,因为白天人都在客厅活动,空气里的细菌比别的地方更多。仅有一个市民认为厨房最脏,市民陆女士说:“厨房油烟大,空气里的细菌也应该很多。”
到底谁说的对呢?我们用科学的方法揭晓。
>>实验目的:家里哪个部位细菌最多
>>实验机构:西安交大医学部免疫学与病原生物学系微生物学实验室
>>实验人员:华商报记者、西安交大医学部免疫学与病原生物学系微生物学教授徐纪茹
>>实验工具:细菌培养皿18个,恒温培养箱
>>实验样本:三个家庭
第一个家庭:严女士家。严女士家常年两个人,严女士和7岁多儿子,她的爱人工作在外地,一年回家几次。严女士的家位于含光路一小区内,房子不临马路。严女士说,家里基本每天扫一次,一周大扫除一次。
第二个家庭:赵女士家。赵女士家一家三口,爱人每天早出晚归,孩子上幼儿园,也是早上走下午接回家。赵女士说,自己每天送完孩子后,就把家里的卫生打扫一次,发现家里有些脏的时候,就会做一次大扫除。赵女士的家在锦业路一个小区,位于小区中间,不临马路。
第三个家庭:王先生家。王先生一家五口,有老人和孩子,王先生和爱人每天朝九晚五上班,孩子上学。两个老人平时在家里。家里每天都会扫地,但一周拖地三次左右,一周大扫除一次。王先生的家在西部大道附近,临着马路。
>>实验步骤:
将培养皿分别放置每个家庭的客厅、厨房、卫生间,每个房间放置两个培养皿,揭开培养皿的盖子。其中,厨房的培养皿一个放在灶台处,一个放在案板处;客厅的培养皿一个放在电视柜处,一个放在沙发处;卫生间的培养皿一个放在马桶后方,一个放在洗漱台上。一个小时之后,收起培养皿,盖上盖子,送往实验室。
将3组18个培养皿放置西安交大医学部免疫学与病原生物学系微生物学实验室,培养24小时,观察最终结果。
实验结果
厨房比卫生间细菌多 临马路的房子细菌更多
4月21日中午,培养皿在恒温箱被培养了24小时之后,华商报记者来到实验室,找到了徐纪茹教授。
徐教授把三组培养皿放在实验室操作台上,打开盖子,有臭味散发出来。华商报记者看到,培养皿上已经长出了很多黑色、青色的斑点。徐教授说,这就是细菌菌落,也有少量真菌菌落。
放置在严女士家厨房的两个培养皿里,放在灶台处的培养皿里菌落密度很大,放在案板处的稍少一些。而放置在客厅两个培养皿里,都是零星的菌落。严女士家厕所的情况怎么样呢?放置在马桶处的培养皿里面菌落较多,但少于厨房,放在洗漱台上的就稍微少些,但多于客厅。
赵女士家的情况相似,厨房灶台处的培养皿里,布满了被黑色的菌落,案板处、客厅和卫生间的培养皿里,菌落明显减少。
王先生家的情况最严重,厨房灶台处的培养皿里,一眼看去全是密集的菌落,案板处少些。卫生间马桶、洗漱台的培养皿里,菌落比厨房稍少,但比严女士家和赵女士家多。王先生家卫生间的培养皿里,放在马桶处的培养皿里的菌落要比洗漱台的多。
徐纪茹教授说:“通过比较,我们就可以找到规律,这三个家庭,都是厨房的菌落数最多,其次是卫生间,客厅最少。而这三个家庭中,临着马路的家庭,几乎每项都比不临马路的菌落数多,这也能说明,临着马路的房子受环境的影响,细菌更多一些。”
专家释疑
为什么厕所比厨房细菌少 细菌对人有害吗
实验结果是不是让你大跌眼镜?
徐纪茹教授解释说:“现代家庭里,厕所使用的都是抽水马桶,大家平时用完厕所会立即冲水,排泄物不会停留,细菌不容易滋生。洗手洗脸洗完后,也会冲洗面盆,细菌不会停留。另外,卫生间就是上厕所时使用,其实是家庭里去的频率最低的地方,因此,厕所里面的环境,不似以往旱厕里面的那么脏。”
“每个家庭几乎每天都做三顿饭,要在厨房里加工食物,生的食物本身就带有很多细菌,而所有食物都具有丰富的营养,是细菌良好的培养基,所以有利于细菌的生长。此外,炒菜时油烟比较大,又不可能天天清理抽油烟机,细菌就更容易黏附滋生了。这也就是为什么灶台上的细菌比案板上多的原因。”
那么,这些细菌都有致病性吗?
徐纪茹教授说:“大家不要紧张,这些细菌都是环境微生物,它们对人体本身是没有危害的。空气中原本就有一些细菌存在,即使是致病细菌,也必须达到一定的量才会对人体有害。”
徐纪茹表示,正常人在这样的环境里生活,不会受到影响,但家里如果有老人体弱者,或者刚出生的新生儿或小婴儿,还是应该注意,多打扫卫生,厨房的灶台、案板要认真清洁,必要的情况下消毒处理,确保细菌的浓度不会太高。



